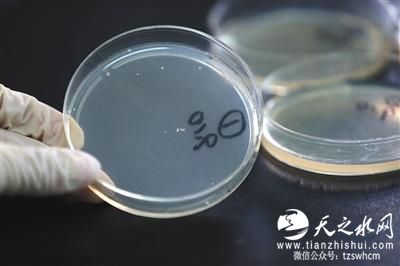
自制月饼调查：微生物超标 卫生状况堪忧

9月11日,东单,一号月饼培养基内出现细菌(盒内小白点)。新京报记者 薛珺 摄

9月11日,东单,6种待检月饼检测微生物含量。新京报记者 薛珺 摄

新京报讯 (记者信娜)近期,国家食药监总局专项抽检品牌月饼,发现仍有部分品牌月饼出现微生物超标情况。品牌月饼尚且如此,自制月饼情况如何?记者随机购买了六款月饼进行检测,检测结果发现,其中一款自制月饼微生物超标;此外,部分月饼在室温下存放较长时间后,也出现了微生物增长甚至超标的情况。
近日,国家食药监总局专项抽检月饼379批次,抽样检验项目合格样品369批次,不合格样品10批次,样品检验合格率为97%。
记者发现,不合格月饼大多涉及微生物超标,10批次不合格样品中,有2批次涉及霉菌超标,最高的超标2.2倍。其余8批次月饼均为菌落总数超标,其中,哈尔滨市一家食品店销售的五仁馅裕昌月饼菌落总数检出值为4900CFU/g,超标2.3倍。
品牌包装月饼尚且如此,自制月饼的情况如何呢?近日,记者分别来到北京市劲松路、月坛北街等附近小商场及蛋糕店,随机购买了四款自制月饼和两款知名品牌的包装月饼,送去实验室进行了微生物检测。
实验结果发现,四款自制月饼中,三款检出微生物,其中一款检测出微生物超标,其菌落总数达2000CFU/g,而相关标准规定最高限值为1500CFU/g;另一款月饼霉菌检出值为100CFU/g,相关标准规定为不超过100CFU/g,涉及超标。
此外,根据实验结果,在常温下储存24小时至30小时后,部分自制月饼内微生物数量逐渐增加,最终超标。其中一款未超标月饼,在储存超过30小时后,菌落总数检出值为2000CFU/g,已超标。
中国农业大学食品与营养工程学院院长罗云波介绍,月饼在原料、加工、运输等多个方面要求较高,如达不到要求容易出现微生物污染。
中国农业大学食品科学与营养工程学院副教授朱毅表示,自制月饼缺乏规范,被污染的可能性更大。朱毅建议,由于目前温度较高,容易滋生微生物,最好将月饼放在冰箱,既可抑制微生物生长,还可抗氧化。
●实验地点:某大学微生物实验室
●实验样品:四款自制月饼;两款某品牌月饼
●实验过程:
1、制作固体培养基。在无菌条件下,将样品月饼取样,并加入试剂。离心后,把上层清液取出加入固体培养基中。用涂菌玻璃刮将清液均匀划开。在恒温箱中培养24小时后,观察并计算菌落总数。
2、将6个样品在室温及相同环境条件下,分别培养24小时及30小时。后重复步骤一,培养后计算菌落总数。
●实验结果:见上表
●实验分析:实验人员观察培养基中细菌后,认为2号样品中检出霉菌。此外,实验人员介绍,根据实验结果,如果月饼本身存在微生物,室温下培养时间越长,菌落总数也会越多。她说,月饼馅中营养丰富,某种程度上相当于细菌的天然培养基。
【释疑1】
哪些环节易致微生物超标?
采访中,多名专家表示,月饼的选材、制作、运输等环节要求较高,稍不留神,就会被污染。罗云波介绍,馅料的选材是否新鲜、加工环境是否清洁卫生,都会成为月饼是否会被污染的影响因素。
朱毅认为,月饼加工、原材料等多个方面的疏忽,均会导致月饼被微生物侵入。她举例,月饼加工过程中,烘焙的中心温度应达到85℃,包装也需在一个小时内完成,并使用脱氧剂等。如果生产环境不够清洁,或者未严格达到标准,都会最终导致月饼的菌落总数超标。
原材料也是影响因素之一。朱毅说,某些生产者为压低成本,选择原材料质量较差,不够新鲜,也会导致月饼容易变质腐败。同时,她指出,近几年,随着健康饮食观念深入,月饼的含糖及含油量均在下降。“糖和油对微生物有抑制作用,用量变少,会增加微生物超标风险”。
朱毅认为,某些品牌加工厂尚且无法满足要求,自制月饼微生物超标的风险则更大。她解释,自制月饼的生产场所动态性较强,整个加工环境相对粗放。加工量大的时候,一些家庭或者小型加工场所很难严格按照标准制作,“隐患较大”。
【释疑2】
三五天不食用该如何储存?
实验数据反映,月饼在常温下长时间存放,会导致微生物不断增加,甚至出现微生物超标情况。罗云波解释,如果月饼本身菌落数超标,常温下再存放10天半个月,就会发霉变质。
采访中,上述食品专家均建议月饼最好冷藏。罗云波说,冷藏可抑制微生物生长。在自制月饼无包装的情况下,可用食品级别的食品袋将月饼独立包装并封闭,放在冰箱内储存。
朱毅也建议,如果3-5天内食用,可放在冰箱冷藏室。她解释,月饼内含油,易氧化,放在冰箱内能够保持味道更鲜美。一个星期以上未食用则最好放在冰箱冷冻室。朱毅说,这样可以抑制微生物生长,也可抗氧化。
带包装的月饼是否就能抑制微生物增加?罗云波认为,外包装可以适当隔绝污染,但也有带来二次污染的可能。如果包装本身不清洁,未达到食品级别,甚至会引入其他污染源。
■ 探访
商家称室温下可放一个月
时值中秋节,蛋糕店甚至私人厨房等都推出了自制月饼。记者探访了一家蛋糕店,其橱窗内均匀码放着数十块不同馅料的月饼,无任何外包装。记者选购了其中一款,售货员直接将其装入塑料袋内。
在向其询问月饼生产日期时,店员回答说“这两天刚做的”,并告知不需要特别措施,室温下就可储存一个月。然而根据实验检测,这款月饼菌落总数检出值为1200CFU/g,常温下贮存30小时后微生物含量超标。
在朱毅看来,自制月饼卫生状况堪忧,“没有生产日期、产地、保质期,什么都没有”,甚至可称五无产品。
此外,一些市民会选择在微商购买号称“手工无添加”月饼。在经过长达几天的物流运输后,到手的月饼却很可能已被微生物污染。
朱毅说,月饼运输也需遵从一定规范,首先不能和有毒有害物品放在一起。其次如果某些自制月饼称其未添加防腐剂,则需保证全程冷链运输。否则很容易被污染。
正文已结束,您可以按alt+4进行评论


已有0人发表了评论